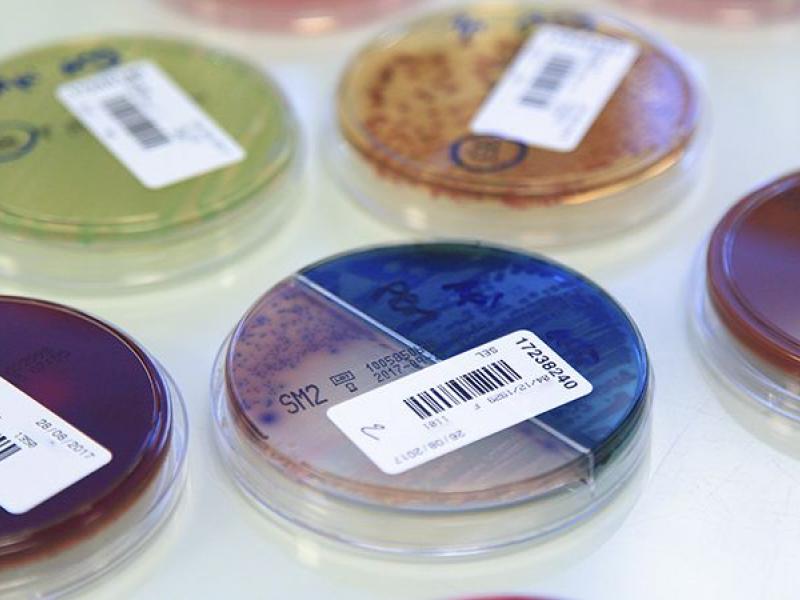
Research Petri dish

The University of Missouri School of Medicine’s Department of Neurology has added new fellowships in 2019.
...
(6/26/19) By studying bones, MU researcher, Dr. Dana Duren, finds evidence of accelerated development in children.
...

Awards and Honors
School of Medicine Honors Outstanding Staff Members
(5/31/19) The University of Missouri School of Medicine and the Staff Advisory Committee held a
...
(2/5/19) Seth L. Sherman, MD, a sports medicine orthopaedic surgeon at University of Missouri Health
...
(1/28/19) Cancer growth might be slowed in glioblastoma cells treated with antioxidants and a standard
...
(12/21/18) The University of Missouri School of Medicine Department of Otolaryngology participated in a multi-institutional
...
(12/17/18) Children born in the most recent century have bones that reach full maturity earlier
...
(12/7/18) - Recent grant awards are examples of the symbiotic relationship between the MU School
...